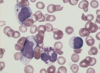

(2) Diseases of the Immune System II (Singh) Flashcards
(77 cards)
What is allorecognition?
The ability of an individual organism to distinguish its own tissues from those of another
What is the direct pathway for Allorecognition?
Donor organ carries an APC cell
Donor APC cell makes contact with host immune system
This initiates a targeted attack toward graft

What is the indirect pathway for Allorecognition?
Recipient’s APCs investigate the contents of the graft cells
Recipient’s APCs recognize graft as non self and elicit a targeted response against graft
This is a B and T cell response against the graft

Which of the following is B-cell mediated?
Hyperacute rejection
Acute rejection
Acute antibody-mediated rejection
Chronic rejection
Chronic antibody-mediated rejection
Hyperacute rejection
Acute antibody-mediated rejection
Chronic antibody-mediated rejection
*Anything with antibody in it is gonna be B cell mediated
What is the mechanism of a hyperacute rejection reaction?
Mediated by pre-formed antibodies
Accounts for the extremly quick response! Antibodies already exhist in host to act on graft!
In particular…Blood antibodies (ABO)

What type of antibody mediated rejection is this?

Acute Antibody-mediated rejection
*Note: Also do a Complement C4d stain to confirm this is acute antibody-mediated rejection

What type of antibody mediated rejection is this?

Chronic antibody-mediated rejection

What is this histologic image revealing?

Acute cellular rejection (T-cell mediated)
Tubulitis
Why do we care about the mechanism behind these different types of graft rejection?
Treatment is very different!!!
The way you treat a T-lymphocyte mediated cellular rejection is very different from an Antibody-mediated (humoral) rejection
What do we have to remember when we treat a patient with graft rejection?
There is no more rejection…
BUT!!!!
There are going to be issues because you induced Immunosuppression
Your patient is more prone to:
- Infections
- Tumors
What specific viral infection are immunosuppressed from transplant patients suseptible to?
VIRAL = Polyomavirus
What is the major occurance with a hematopoietic stem cell transplant?
Brand new immune system!!!
What is graft vs. host disease?
T-lymphocyte mediated response of the GRAFT against the host!
Common with bone marrow transplant.
Can occur when graft contains immune cells from donor

What are some common manifestations of graft vs. host disease?
Reactions in:
Skin - (rash –> desquamation)
Liver - (jaundice –> cholestasis)
Intestines - (bloody diarrhea –> strictures)
Chediak Higashi Syndrome
Inheritance pattern?
Mechanism?
AR
Failure of phagolysosomal function

Is the mechanism of Chediak Higashi syndrome microscopically visualized?
YES!
The failure of phagolysosomal fusion can be seen on a peripheral blood smear
*You can see GIANT granules in neutrophils.
What is the major clinical presentation of chediak higashi syndrome?
Albanism!!!
Defects in melanocytes lead to albanism or grey hair streaks in Chediak Higashi syndrome pts

Chronic granulomatous disease
How is it aquired?
Mechanism?
Genetically
Failure of superoxide production within phagocytes. Accumulation of macrophages“walls off” the infection because the innate immune system is compromised and cannot handle the infection!

Membrane attack complex deficiency
What is affected?
What happens without MAC?
What infections are common?
Terminal components C5, 6, 7, 8, 9
Without the final MAC, the lysis of the microbial membrane can’t occur
Neisseria infections, Meningitis
Hereditary angioedema
Genetic inheritance pattern?
Mechanism?
AD
Deficiency of C1 inhibitor

What are the symptoms of hereditary angioedema?
Facial swelling
Airway constriction
Intestinal swelling
TONS OF SWELLING OVERALL
*Remember, this is NOT an autoimmunity deficiency. It’s randomly here. meh.

Severe Combined Immunodeficiency (SCID)
What are two major facets of this disease?
“Bubble” “Boy”
“Bubble” –> Such a severe immunodeficiency, knocking out T and B cell response. Need to be isolated from pathogens
“Boy” –> X-linked, FAR more common in boys
What is the treatment for severe combined imunodeficiency (SCID)?
Stem cell transplantation
Gene therapy
DiGeorge Syndrome
What are the primary causes?
Primary deficiency of T lymphocytes: due to failure of pharyngeal pouches 3/4, thymus, parathyroids, heart, great vessels are affected
Genetic: 22q11 deletions




















